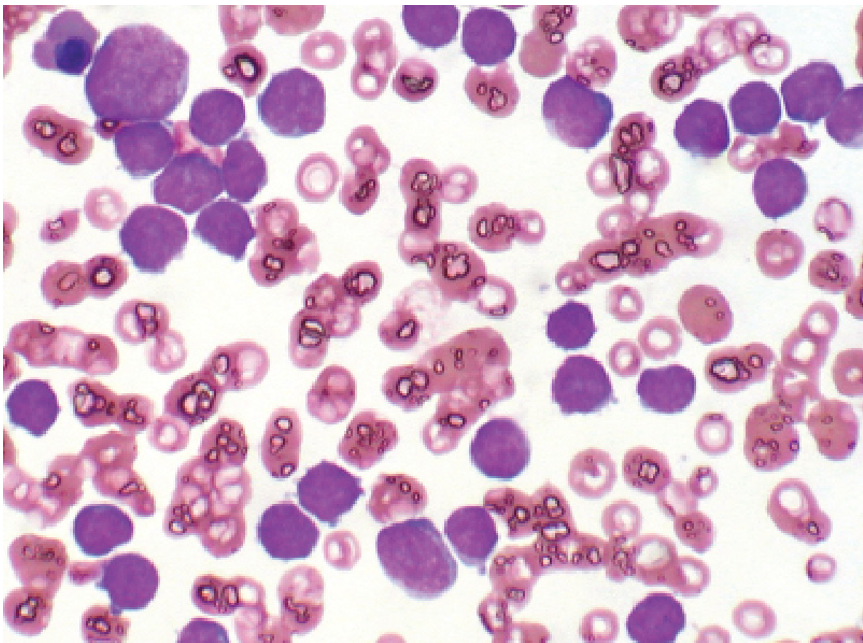
\-arise from embryonic mesodermal origin 

\-composed of spindle cells arranged in streams and bundles

\-bengin tumors use suffix -oma

\-malignant tumors use sarcoma

Pathology and Disease Exam 5/6
0.0(0)
Studied by 7 peopleCard Sorting
1/68
Earn XP
Description and Tags
Last updated 4:42 AM on 4/17/23
Name | Mastery | Learn | Test | Matching | Spaced | Call with Kai |
|---|
No analytics yet
Send a link to your students to track their progress
69 Terms
1
New cards
What is Neoplasia?
\-process of new growth
\-normal cells undergo irreversible genetic changes and makes them unresponsive to ordinary controls on growth
\-due to the transformed cell within
\-normal cells undergo irreversible genetic changes and makes them unresponsive to ordinary controls on growth
\-due to the transformed cell within
2
New cards
What are the other two common terms for neoplasms?
\-tumor (“swelling”)
\-Cancer (“crab”)
\-Cancer (“crab”)
3
New cards
What is oncology?
\-the study of neoplasia
4
New cards
What does the word oncos mean?
\-tumor
5
New cards
What does “cancer” denote?
\-a malignant growth
6
New cards
True or False: “Tumor” or “mass” may be neoplasm or a nonneoplastic lesion like a granuloma
TRUE!
7
New cards
What does neoplasm mean?
\-cancerous
8
New cards
What does nonneoplastic lesion mean?
\-non-malignant
\-benign
\-benign
9
New cards
Meaning of Benign
\-harmless
\-do not invade surrounding tissue
\-do not spread to new anatomic locations within the body
\-curable and are rarely responsible for death of an animal
\-do not invade surrounding tissue
\-do not spread to new anatomic locations within the body
\-curable and are rarely responsible for death of an animal
10
New cards
Meaning of Malignant
\-harmful
\-invade locally
\-spread by metastasis (change of place)
\-kill animal by interfering with critical body functions
\-invade locally
\-spread by metastasis (change of place)
\-kill animal by interfering with critical body functions
11
New cards
What is the exception for benign nervous system tumors?
\-even though it is benign, can cause death due to it being in the nervous system
12
New cards
Cells go from Normal to Preneoplastic to Neoplastic, what are the 4 preneoplastic changes to cells
\-Hypertrophy
\-Hyperplasia
\-Metaplasia
\-Dysplasia
\-Hyperplasia
\-Metaplasia
\-Dysplasia
13
New cards
Mesenchymal Tumors
\-arise from embryonic mesodermal origin
\-composed of spindle cells arranged in streams and bundles
\-bengin tumors use suffix -oma
\-malignant tumors use sarcoma
\-composed of spindle cells arranged in streams and bundles
\-bengin tumors use suffix -oma
\-malignant tumors use sarcoma
14
New cards
Define Fibrosarcoma
\-malignant tumor (mesenchymal tumor) composed of fibroblasts
15
New cards
True or False: The cells of the Hematopoietic system are also mesenchymal?
True
16
New cards
Are lymphoma and lymphosarcoma the same thing?
yes, they are both malignant in this case
17
New cards
Suffix Oma meaning
\-benign tumors
18
New cards
suffix sarcoma meaning
\-malignant tumors
19
New cards
Malignant form of tumor that arises from Chondrocytes
\-Chondrosarcoma

20
New cards
Malignant form of tumor that arises from Osteocytes
Osteosarcoma

21
New cards
Benign form of tumor that arises from Chondrocytes
\-Chondroma
22
New cards
Benign form of tumor that arises from Osteocytes
\-osteoblastoma
23
New cards
What is the difference between Oma and carcinoma?
\-oma is from mesenchymal origin (benign)
\-carcinoma (cancers)is all malignant tumors of epithelial origin
\-carcinoma (cancers)is all malignant tumors of epithelial origin
24
New cards
What is the difference between adenoma and adenocarcinoma?
\-ademona is a benign tumor arising from glandular epithelium (ex. mammary epithelium)
\-adenocarcinoma is a malignant tumor having a glandular growth pattern (epithelium)
\-adenocarcinoma is a malignant tumor having a glandular growth pattern (epithelium)
25
New cards
Epithelioma
\-benign tumor of epithelial cells
26
New cards
Fibroma
\-benign tumor of fibrocytes
27
New cards
Chondroma
\-benign tumor of chondrocytes
28
New cards
Adrenocarcinomas
\-malignant tumor derived from glandular epithelium

29
New cards
Squamous cell carcinomas
\-malignant tumor of squamous cell from epithelial

30
New cards
What is a mixed tumor?
\-a tumor containing multiple cell types
\-arise from a single pluripotent or totipotent stem cell capable of differentiating into a variety of more mature cell types
\-arise from a single pluripotent or totipotent stem cell capable of differentiating into a variety of more mature cell types
31
New cards
What is a teratoma?
\-arise from totipotential germ cells
\-contain tissues normally derived from all three embryonic cell layers
\-may be composed of a bizarre mixture of adult and embryonic tissue types
\-benign
\-contain tissues normally derived from all three embryonic cell layers
\-may be composed of a bizarre mixture of adult and embryonic tissue types
\-benign
32
New cards
What is a hamartoma?
\-disorganized but mature mesenchymal or epithelial tissues found in their normal anatomic location
\-consist of abnormal proliferations of blood vessels
\-consist of abnormal proliferations of blood vessels

33
New cards
What is choristomas
\-composed of normal mature tissue located at an ectopic site (out of place)
34
New cards
What is a dermoid?
\-a mass consisting of mature skin and adnexa
\-may be found in a variety of unusually site, including the cornea
\-may be found in a variety of unusually site, including the cornea

35
New cards
Characteristics that make up a tumor
\-may arise from virtually any normal tissue in the body
\-benign tumors are expansile masses and may compress but do not invade surrounding tissue and do not spread to other sites in the body
\-malignant tumors are locally invasive and have the potential to metastasize to distant sites
\-benign tumors are expansile masses and may compress but do not invade surrounding tissue and do not spread to other sites in the body
\-malignant tumors are locally invasive and have the potential to metastasize to distant sites
36
New cards
3 tumor characteristics
\-loss of differentiation
\-unlimited proliferative potential
\-tumor grade and stage (extent of spread)
\-unlimited proliferative potential
\-tumor grade and stage (extent of spread)
37
New cards
Differences between Benign and Malignant
\-benign=generally expansile and may compress adjacent tissue
\-malignant= usually invasive, alterations to cell adhesion, motility, and protease production allow tumor cells to leave the tumor and penetrate surrounding tissue, become completely independent of local growth regulatory controls and acquire an independent blood supply
\-malignant= usually invasive, alterations to cell adhesion, motility, and protease production allow tumor cells to leave the tumor and penetrate surrounding tissue, become completely independent of local growth regulatory controls and acquire an independent blood supply
38
New cards
Anaplasia
\-poor differentiation
\-loss of differentiation of cells and of their orientation to one another
\-loss of differentiation of cells and of their orientation to one another
39
New cards
Anisocytosis
\-wide variation in cell size
40
New cards
Pleomorphism
\-wide variation is cell shape and size
41
New cards
Anisokaryosis
\-extreme variability in nuclear size
42
New cards
Differentiation Therapy
\-tumor cells can be forced to differentiate into more mature, near-normal cells
43
New cards
Steps a cell goes through from normal to abnormal (3 steps)
\-Initiation
\-Promotion
\-Progression
\-Promotion
\-Progression
44
New cards
Initiation Step
\-an irreversible alteration of genetic material
45
New cards
Promotion Step
\-the selective outgrowth of initiated cells to form a benign tumor
46
New cards
Progression Step
\-the gradual development of features of malignancy due to a combination of genetic and epigenetic changes
47
New cards
Define three major ways the tumor interacts with tissue?
\-Tumor-stromal interactions
\-Tumor Immunity
\-Paraneoplastic effects
\-Tumor Immunity
\-Paraneoplastic effects
48
New cards
Tumor-stromal interactions
\-tumor cells and their stroma exert considerable mutual control by interacting via signaling molecules
\-growth factors, cytokines, hormones, and inflammatory mediators
\-modulate the growth rate, differentiation state, and behavior if both stroll and tumor cells
\-growth factors, cytokines, hormones, and inflammatory mediators
\-modulate the growth rate, differentiation state, and behavior if both stroll and tumor cells

49
New cards
Tumor Immunity
\-the immune system may recognize tumor antigens as foreign and destroy tumor cells
\-Innate immune system and the adaptive immune system
\-Tumor cells may employ a number of strategies to evade immunosurveillance
\-Innate immune system and the adaptive immune system
\-Tumor cells may employ a number of strategies to evade immunosurveillance
50
New cards
Innate immune system
\-natural killer cells, macrophages
51
New cards
Adaptive immune system
\-cytotoxic T lymphocytes, B lymphocytes
52
New cards
Paraneoplastic effects
\-Tumors cause clinical disease through direct means, such as compression or effacement of normal tissues
\-OR Paraneoplastic effects, such as the secretion of hormones by the tumor
\-OR Paraneoplastic effects, such as the secretion of hormones by the tumor
53
New cards
Parenchyma
\-a tumor consists of the tumor cells proper
54
New cards
Stroma
\-nonneoplastic supporting structure
\-composed of extracellular connective tissue, proteins, glycoproteins (collagen)
\-composed of extracellular connective tissue, proteins, glycoproteins (collagen)
55
New cards
What is an interstitial cell tumor?
\-lies within the testis and is surrounded by a thick connective tissue capsule
\-fibrous capsules are common surrounding benign tumors than surrounding malignant tumors
\-fibrous capsules are common surrounding benign tumors than surrounding malignant tumors
56
New cards
Describe the development and composition of a squamous cell carcinoma.
\
\
\-**Carcinomas and adenocarcinomas that stimulate the formation of abundant collagen in surrounding connective tissue (desmoplasia) may be termed “scirrhous.”**
\-**Tumor-associated fibroblasts may secrete a fetal type of extracellular matrix and coevolve with adjacent tumor cells.**
\-**Tumor-associated fibroblasts may secrete a fetal type of extracellular matrix and coevolve with adjacent tumor cells.**
57
New cards
What is angiogenesis?
\-Tumors depend absolutely on an adequate blood supply to provide oxygen and nutrients to tumor cells.
\-Without the development of new blood vessels tumors are limited to a maximum diameter of 1 to 2 mm.
\-Without the development of new blood vessels tumors are limited to a maximum diameter of 1 to 2 mm.
58
New cards
What is Lymphangiogenesis?
\-The development of lymphatic vasculature in tumors, termed, shares many features with tumor angiogenesis.
\-Tumor-associated lymphatic vessels sprout from preexisting lymphatic vessels in response to tumor-secreted factors such as VEGF.
\-Tumor-associated lymphatic vessels are essential for metastasis of solid tumors to regional lymph nodes.
\
\-Tumor-associated lymphatic vessels sprout from preexisting lymphatic vessels in response to tumor-secreted factors such as VEGF.
\-Tumor-associated lymphatic vessels are essential for metastasis of solid tumors to regional lymph nodes.
\
59
New cards
How does inflammation occur within a tumor?
\-**I**nflammatory cells are attracted to tumors by chemokines and cytokines released by tumor cells.
\-In general, inflammation does not appear to protect against tumors.
\-In fact, many chronic inflammatory conditions increase the risk for cancer in affected organs.
\-In general, inflammation does not appear to protect against tumors.
\-In fact, many chronic inflammatory conditions increase the risk for cancer in affected organs.
60
New cards
Vaccine-associated sarcomas in cats is clearly linked to the presence of …
\-inflammation at sites of inoculation

61
New cards
What is immunosurveillance?
62
New cards
\
What is a tumor specific shared antigen?
What is a tumor specific shared antigen?
63
New cards
What are differentiation antigens?
64
New cards
What is an antitumor effect mechanism?
65
New cards
What are the four steps in Evasion to Immune Responses
66
New cards
What is Tumor immunotherapy?
67
New cards
How do tumors disseminate? What are the steps of tumor dissemination?
68
New cards
What is Metastasis suppression?
69
New cards
What is a Transmissible tumor? \n \n